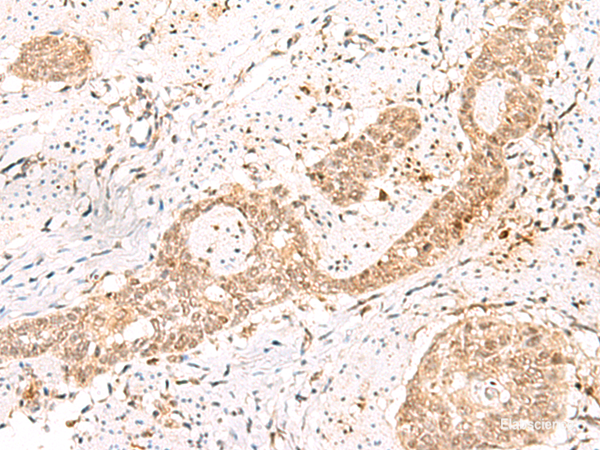
Anti-PRKAG2

Cookie preferences
This website uses cookies, which are necessary for the technical operation of the website and are always set. Other cookies, which increase the comfort when using this website, are used for direct advertising or to facilitate interaction with other websites and social networks, are only set with your consent.
Configuration
Technically required
These cookies are necessary for the basic functions of the shop.
"Allow all cookies" cookie
"Decline all cookies" cookie
CSRF token
Cookie preferences
Currency change
Customer-specific caching
FACT-Finder tracking
Individual prices
Selected shop
Session
Comfort functions
These cookies are used to make the shopping experience even more appealing, for example for the recognition of the visitor.
Note
Show the facebook fanpage in the right blod sidebar
Statistics & Tracking
Affiliate program
Conversion and usertracking via Google Tag Manager
Track device being used
If you have any questions, please use our Contact Form.
You can also order by e-mail: info@biomol.com
Larger quantity required? Request bulk
You can also order by e-mail: info@biomol.com
Larger quantity required? Request bulk
AMP-activated protein kinase (AMPK) is a heterotrimeric protein composed of a catalytic alpha... more
Product information "Anti-PRKAG2"
AMP-activated protein kinase (AMPK) is a heterotrimeric protein composed of a catalytic alpha subunit, a noncatalytic beta subunit, and a noncatalytic regulatory gamma subunit. Various forms of each of these subunits exist, encoded by different genes. AMPK is an important energy-sensing enzyme that monitors cellular energy status and functions by inactivating key enzymes involved in regulating de novo biosynthesis of fatty acid and cholesterol. This gene is a member of the AMPK gamma subunit family. Mutations in this gene have been associated with Wolff-Parkinson-White syndrome, familial hypertrophic cardiomyopathy, and glycogen storage disease of the heart. Alternate transcriptional splice variants, encoding different isoforms, have been characterized. PRKAG2 (Protein Kinase AMP-Activated Non-Catalytic Subunit Gamma 2) is a Protein Coding gene. Diseases associated with PRKAG2 include Glycogen Storage Disease Of Heart, Lethal Congenital and Wolff-Parkinson-White Syndrome. Among its related pathways are RET signaling and Regulation of TP53 Activity. GO annotations related to this gene include protein kinase binding and protein kinase activator activity. An important paralog of this gene is PRKAG1. Protein function: AMP/ATP-binding subunit of AMP-activated protein kinase (AMPK), an energy sensor protein kinase that plays a key role in regulating cellular energy metabolism. In response to reduction of intracellular ATP levels, AMPK activates energy-producing pathways and inhibits energy-consuming processes: inhibits protein, carbohydrate and lipid biosynthesis, as well as cell growth and proliferation. AMPK acts via direct phosphorylation of metabolic enzymes, and by longer-term effects via phosphorylation of transcription regulators. Also acts as a regulator of cellular polarity by remodeling the actin cytoskeleton, probably by indirectly activating myosin. Gamma non-catalytic subunit mediates binding to AMP, ADP and ATP, leading to activate or inhibit AMPK: AMP-binding results in allosteric activation of alpha catalytic subunit (PRKAA1 or PRKAA2) both by inducing phosphorylation and preventing dephosphorylation of catalytic subunits. ADP also stimulates phosphorylation, without stimulating already phosphorylated catalytic subunit. ATP promotes dephosphorylation of catalytic subunit, rendering the AMPK enzyme inactive. [The UniProt Consortium]
| Keywords: | Anti-PRKAG2, Anti-H91620p, Anti-AMPK gamma2, Anti-AMPK subunit gamma-2, Anti-5'-AMP-activated protein kinase subunit gamma-2, PRKAG2 Polyclonal Antibody |
| Supplier: | Elabscience |
| Supplier-Nr: | E-AB-52889 |
Properties
| Application: | IHC, ELISA |
| Antibody Type: | Polyclonal |
| Conjugate: | No |
| Host: | Rabbit |
| Species reactivity: | human, mouse |
| Immunogen: | Fusion protein of human PRKAG2 |
Database Information
| KEGG ID : | K07200 | Matching products |
| UniProt ID : | Q9UGJ0 | Matching products |
| Gene ID : | GeneID 51422 | Matching products |
Handling & Safety
| Storage: | -20°C |
| Shipping: | 4°C (International: -20°C) |
Caution
Our products are for laboratory research use only: Not for administration to humans!
Our products are for laboratory research use only: Not for administration to humans!
Information about the product reference will follow.
more
You will get a certificate here
Viewed


